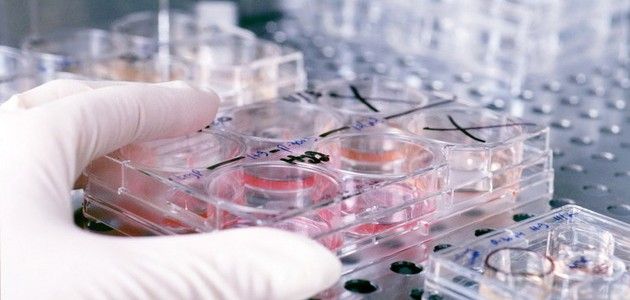
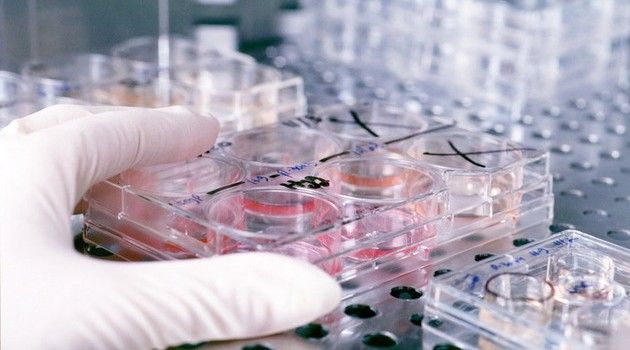

Riscul de schizofrenie al unei persoane este crescut în cazul în care moștenește variante specifice ale unei gene având legătură cu „tăierile sinaptice”, adică eliminarea conexiunilor dintre neuroni, relevă un studiu bazat pe analiză genetică efectuat de cercetătorii de la Stanley Center for Psychiatric Research din cadrul Broad Institute, Harvard Medical School, Boston Children’s Hospital, Michael Carroll, profesor la Harvard Medical School, și principalul autor Aswin Sekar, de la Harvard Medical School, ale cărui rezultate au fost publicate în revista „Nature”, informează site-ul broadinstitute.org.
Aceste constatări indică pentru prima oară că originea acestei boli psihice devastatoare este cauzal legată de variante ale unei gene specifice și de un proces biologic. De asemenea, ele ajută la explicarea unor observații vechi de decenii: tăierea sinaptică este deosebit de activă în timpul adolescenței, care este perioada tipică de debut pentru simptomele schizofreniei, creierul pacienților cu schizofrenie tinzând să indice mai puține conexiuni între neuroni.
Gena numită „componenta complement 4” (C4), joacă un rol bine-cunoscut în sistemul imunitar, însă acum s-a dovedit că joacă și un rol-cheie în dezvoltarea creierului și în riscul de schizofrenie. Perspectiva poate permite viitoarelor strategii terapeutice să fie îndreptate mai degrabă spre rădăcinile tulburărilor, decât spre simptome.
Studiul are potențialul de a revigora cercetarea translațională a unei boli debilitante. Schizofrenia este o tulburare psihiatrică devastatoare care afectează un procent din populație și se caracterizează prin halucinații, retractilitate emoțională și un declin al funcției cognitive. Aceste simptome apar cel mai frecvent la pacienți atunci când aceștia sunt adolescenți sau adulți tineri. Descrisă pentru prima oară acum mai bine de 130 de ani, schizofrenia nu beneficiază de tratamente foarte eficiente și a cunoscut puține progrese biologice sau medicale în ultima jumătate de secol. În vara anului 2014, un consorțiu internațional, condus de cercetătorii de la Stanley Center din cadrul Broad Institute, a identificat peste 100 de zone din genomul uman care reprezintă factori de risc pentru schizofrenie.
Studiul recent publicat a raportat descoperirea genei specifice care stă la baza celor mai puternici factori de risc și legăturile sale cu un proces biologic specific de la nivelul creierului.
„De când schizofrenia fost descrisă pentru prima dată, în urmă cu un secol, biologia care stă la baza sa este o cutie neagră, în parte pentru că a fost practic imposibilă modelarea tulburării la celule sau animale”, a spus McCarroll. „Genomul uman oferă o nouă cale puternică pentru studierea acestei boli. Înțelegerea acestor efecte genetice asupra riscului este o modalitate de a deschide indiscret acea cutie neagră, cercetând din interior și începând să vedem mecanismele biologice reale”, a adăugat acesta.
„Acest studiu marchează un punct de cotitură important în lupta împotriva bolilor mintale”, a declarat Bruce Cuthbert, directorul interimar al National Institute of Mental Health din Statele Unite. „Pentru că originile moleculare ale bolilor psihice sunt puțin înțelese, eforturile companiilor farmaceutice de a urmări noi tratamente sunt puține și rare. Acest studiu schimbă jocul. Datorită acestei descoperiri genetice, putem vedea în cele din urmă potențialul testelor clinice, depistarea precoce, tratamente noi și chiar prevenția”, a adăugat acesta.
Povestea remarcabilă a acestei descoperiri a implicat colectarea de ADN de la peste 100.000 de oameni, o analiză detaliată a variației genetice complexe a peste 65.000 de genomuri umane, dezvoltarea unei strategii de analiză inovatoare, examinarea probelor de creier postmortem prelevate de la sute de oameni și utilizarea de modele animale pentru a arăta că o proteină din sistemul imunitar joacă un rol nebănuit anterior în creier.
În ultimii cinci ani, geneticienii conduși de Stanley Center for Psychiatric Research din cadrul Broad Institute și colaboratorii săi din întreaga lume au colectat peste 100.000 de mostre de ADN uman din 30 de țări diferite pentru a localiza regiuni ale genomului uman purtătoare ale unor variante genetice care cresc riscul de schizofrenie. De departe, cel mai puternic semnal a fost cromozomul 6, într-o regiune a ADN-ului asociată cu boli infecțioase, provocând pe unii observatori să sugereze că schizofrenia poate fi declanșată de un agent infecțios. Dar cercetătorii nu aveau nici o idee despre care dintre sutele de gene din regiune este, de fapt, responsabilă de această maladie sau despre modul în care aceasta a acționat.
Pe baza analizelor genetice, McCarroll și Sekar au descoperit că structura genei C4 (ADN) ar putea prezice activitatea genei C4 (ARN) din creierul fiecărei persoane și au utilizat aceste informații pentru a deduce activitatea genei C4 din datele genomului la 65.000 de persoane cu și fără schizofrenie. Aceste date au relevat o corelație izbitoare: pacienții care au avut forme particulare structurale ale genei C4 au prezentat o mai înaltă expresie a acestei gene și au avut un risc mai mare de a dezvolta schizofrenie.
De asemenea, ei au descoperit că C4 a jucat un rol-cheie în tăierea sinapselor în timpul maturării creierului. În special, au descoperit că C4 a fost necesară pentru o altă proteină (o componentă complementară numită C3) care se depune pe sinapse, ca un semnal că sinapsele trebuie tăiate. Datele sugerează, de asemenea, că o activitate a C4 mai mare, duce la eliminarea mai multor sinapse din creier, la un moment-cheie din dezvoltarea sa.
Concluziile pot ajuta la explicarea îndelungatului mister de ce creierul persoanelor cu schizofrenie tinde să aibă un cortex cerebral mai subțire, cu mai puține sinapse decât au indivizi neafectați. Cercetarea poate ajuta, de asemenea, la explicarea de ce debutul simptomelor de schizofrenie tinde să apară în adolescența târzie: creierul uman este supus în mod normal, pe scară largă, tăierilor de sinapse în timpul adolescenței, mai ales în cortexul cerebral (stratul exterior al creierului, responsabil pentru multe aspecte ale procesului cognitiv). Tăierea sinaptică excesivă în timpul adolescenței și maturității timpurii, ca urmare a creșterii activității C4, ar putea duce la simptomele cognitive observate la bolnavii de schizofrenie.
Această descoperire îmbogățește înțelegerea asupra acestei maladii iar acest salt nu s-ar fi putut face fără genetică, a spus Stevens. „Suntem departe de a avea un tratament bazat pe aceste descoperiri, dar este interesant să ne gândim că într-o zi am putea fi în măsură să intervenim în procesul de tăiere a sinapselor la unele persoane și să reducem riscul”.
Aceasta este o abordare diferită față de terapiile medicale curente care se ocupă numai de un simptom specific al schizofreniei (psihozele), mai degrabă decât de cauzele tulburării și nu pot opri declinul cognitiv sau alte simptome ale bolii. Cercetătorii americani subliniază faptul că terapiile bazate pe aceste constatări mai au încă nevoie de ani de studii. Totuși, faptul că este deja cunoscut rolul proteinelor complementare în sistemul imunitar înseamnă că cercetătorii pot naviga prin bogăția de cunoștințe existente pentru a identifica posibile abordări terapeutice. De exemplu, medicamente anti-complement sunt deja în curs de elaborare pentru tratarea altor boli.
„Pentru prima data, originea schizofreniei nu mai este o cutie complet neagră”, a declarat Eric Lander, director al Broad Institute care este convins că înțelegerea schizofreniei va accelera progresul împotriva acestei boli devastatoare care îi afectează pe mulți tineri, mai noteazăbroadinstitute.org.
Sursa; agerpres.ro

No comments so far.
Be first to leave comment below.